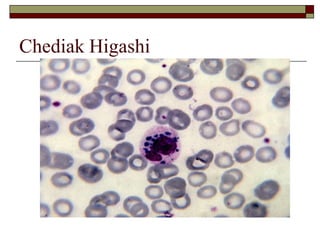
Chediak Higashi
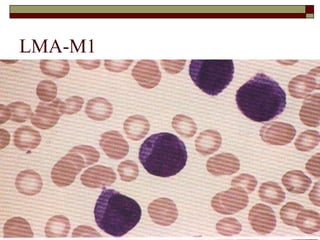
LMA-M1
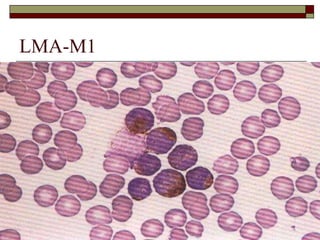
LMA-M1
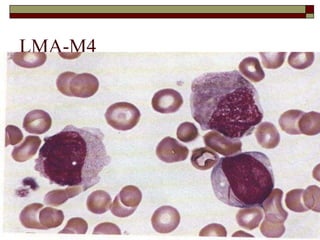
LMA-M4
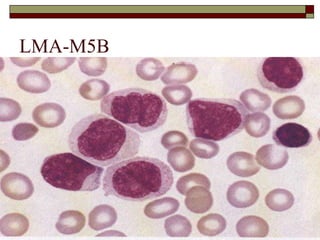
LMA-M5B
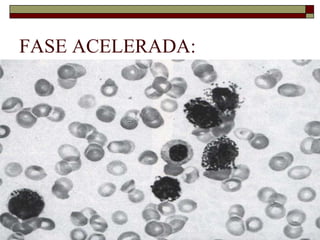
FASE ACELERADA:
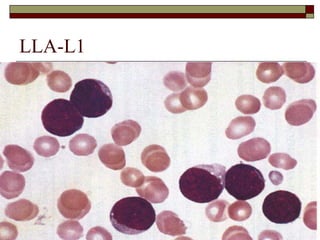
LLA-L1
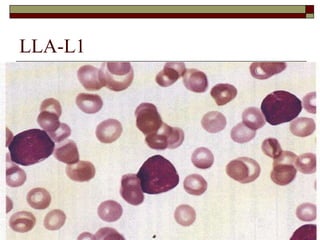
LLA-L1
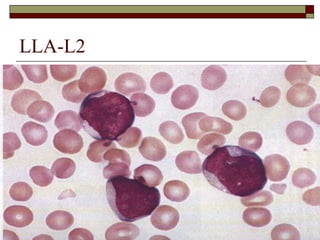
LLA-L2
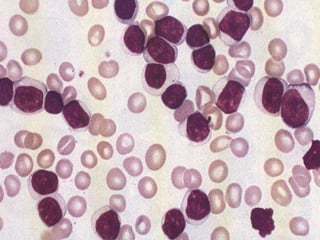
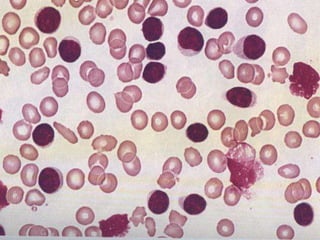
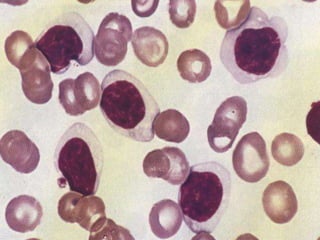
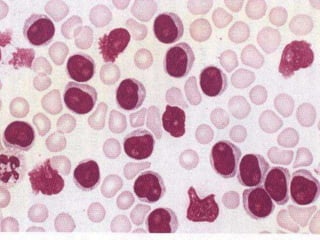
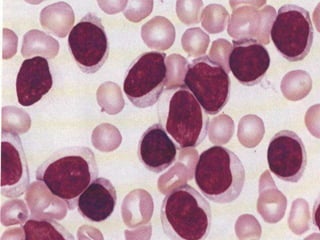
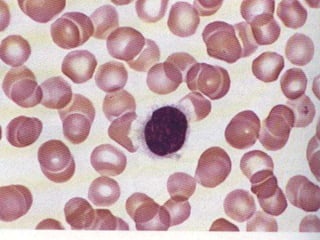
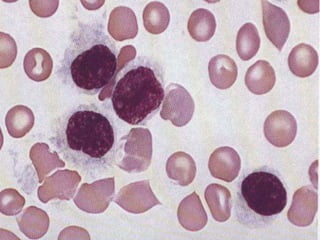

O documento descreve as principais características da maturação da série branca do sangue e das leucemias mielóides agudas. Resume os principais tipos de leucemia mielóide aguda de acordo com a Classificação FAB, incluindo sinais, sintomas, recursos diagnósticos e aspectos citogenéticos e prognósticos.